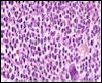

Déclaration de liens d'intérêts
Cet auteur a déclaré n'avoir aucun lien d'intérét
 Si pour cet année Le Parisien constate en effet que « pour une fin d'automne, c'est tout de même très calme sur le front des virus » et que journal indique que « la grippe ne sera pas là avant les fêtes, il ne faut pas baisser les bras. Récemment, la perte de la moitié des approvisionnements américains en vaccin antigrippal du à une contamination a créé une pénurie critique. Si elles savèrent sûres et immunogènes, des doses réduites de vaccin antigrippal administrées par voie intradermique pourraient augmenter le nombre de doses de vaccin disponible.
Si pour cet année Le Parisien constate en effet que « pour une fin d'automne, c'est tout de même très calme sur le front des virus » et que journal indique que « la grippe ne sera pas là avant les fêtes, il ne faut pas baisser les bras. Récemment, la perte de la moitié des approvisionnements américains en vaccin antigrippal du à une contamination a créé une pénurie critique. Si elles savèrent sûres et immunogènes, des doses réduites de vaccin antigrippal administrées par voie intradermique pourraient augmenter le nombre de doses de vaccin disponible.
Les données relatives aux résultats des greffes de sang du cordon chez ladulte sont rares, malgré le fait que ces greffes soient de plus en plus fréquentes. Deux équipes de chercheurs - une américaine et une européenne - ont voulu ainsi comparer les résultats de la greffe de cellules souches hématopoïétiques de donneurs non apparentés chez ladulte leucémique ayant reçu, soit du sang du cordon incompatible pour un seul soit pour deux antigènes HLA. Les résultats ont été publiés dans la dernière édition du New England Journal of Medicine.
Les données relatives aux résultats des greffes de sang du cordon chez ladulte sont rares, malgré le fait que ces greffes soient de plus en plus fréquentes. Deux équipes de chercheurs - une américaine et une européenne - ont voulu ainsi comparer les résultats de la greffe de cellules souches hématopoïétiques de donneurs non apparentés chez ladulte leucémique ayant reçu, soit du sang du cordon incompatible pour un seul soit pour deux antigènes HLA. Les résultats ont été publiés dans la dernière édition du New England Journal of Medicine.